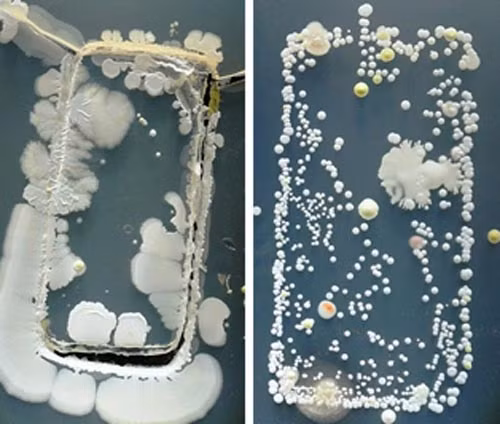
Điện thoại di động khiến mẹ bầu bị bệnh. Điện thoại di động có thể khiến bạn bị ốm vì màn hình điện thoại của bạn chứa rất nhiều vi trùng. Trước khi dùng bữa, bạn thường rửa tay bằng xà phòng khử trùng. Nhưng ngay khi điện thoại sáng lên, bạn sẽ không ngần ngại chạm vào màn hình để kiểm tra thông tin.

![[GALLERY] Mazda CX-5 thế hệ mới "cháy hàng" nhận 10.000 đơn chỉ sau 1 tháng](https://cdn.kienthuc.net.vn/images/9296f0377c64048406d89ea0c83995cbaa2f09cb5010a93da44658e5ded0d5cc2b20e389e8931413b0c20e1edab75815/1-3360.jpg.avif)
![[GALLERY] Skoda Peaq 2027 vừa ra mắt - SUV điện 3 hàng ghế chạy 647 km/sạc](https://cdn.kienthuc.net.vn/images/9296f0377c64048406d89ea0c83995cbaa2f09cb5010a93da44658e5ded0d5ccfcaf26fad2b90e7bcccfd89a226e5054/3-4638.jpg.avif)
![[GALLERY] Tính năng AI miễn phí của Google gây sốt, người Việt dùng cực nhiều](https://cdn.kienthuc.net.vn/images/190e30c7c04ee6e7103089027c41b3a927a43aec4d7578e6a2066dc2517e12a4baf95a50518cc744c6184e1388024d95/ni-1.png.avif)
![[GALLERY] Máy ảnh compact 20 năm tuổi bất ngờ sốt trở lại nhờ Gen Z](https://cdn.kienthuc.net.vn/images/190e30c7c04ee6e7103089027c41b3a9be365bfc1f9dc885057affd4daacee682c9e4462ec7548a38f72f636d0d161fc/anh-2.png.avif)
![[GALLERY] BYD Denza N8L 2027 từ hơn 1,1 tỷ đồng, chạy 430km không "ăn xăng"](https://cdn.kienthuc.net.vn/images/9296f0377c64048406d89ea0c83995cbaa2f09cb5010a93da44658e5ded0d5cc4493aa30b0408a06c2b4a4559307ee2c/11-4458.jpg.avif)
![[GALLERY] Nissan nhá hàng SUV Tekton đậm chất Patrol, "đối thủ" Kia Seltos](https://cdn.kienthuc.net.vn/images/9296f0377c64048406d89ea0c83995cbaa2f09cb5010a93da44658e5ded0d5cc701a69cd11302c0c104f53d3993bdfcd/11-1912.jpg.avif)
![[GALLERY] Mark Zuckerberg chi 15 tỷ USD mua thiên tài 29 tuổi, giờ ra sao?](https://cdn.kienthuc.net.vn/images/190e30c7c04ee6e7103089027c41b3a9cf048880028638b5a5a90c4a05bc07c8fe11c5ed1042dcaa0a9762cfe4a53f99/thien-2.png.avif)
![[GALLERY] Audi A3 2027 trình làng với nội thất "xịn sò", giá từ 36.300 USD](https://cdn.kienthuc.net.vn/images/9296f0377c64048406d89ea0c83995cbaa2f09cb5010a93da44658e5ded0d5cc9666213d3a10691b70f77a6b90b0fcca/13.jpg.avif)
![[GALLERY] Mazda CX-5 thế hệ mới "cháy hàng" nhận 10.000 đơn chỉ sau 1 tháng](https://cdn.kienthuc.net.vn/images/74db2820f1946736a44f941aef7fe4afaa2f09cb5010a93da44658e5ded0d5cc2b20e389e8931413b0c20e1edab75815/1-3360.jpg.avif)
Mazda CX-5 2026 mới đang tạo nên sức hút lớn tại Nhật Bản khi ghi nhận hơn 10.000 đơn đặt hàng chỉ sau một tháng mở bán, cao gấp 5 lần so với mục tiêu ban đầu.
![[GALLERY] Skoda Peaq 2027 vừa ra mắt - SUV điện 3 hàng ghế chạy 647 km/sạc](https://cdn.kienthuc.net.vn/images/fa6fa22794e1049e63e79fd6d1d3f051aa2f09cb5010a93da44658e5ded0d5ccfcaf26fad2b90e7bcccfd89a226e5054/3-4638.jpg.avif)
![[GALLERY] BYD Denza N8L 2027 từ hơn 1,1 tỷ đồng, chạy 430km không "ăn xăng"](https://cdn.kienthuc.net.vn/images/fa6fa22794e1049e63e79fd6d1d3f051aa2f09cb5010a93da44658e5ded0d5cc4493aa30b0408a06c2b4a4559307ee2c/11-4458.jpg.avif)
![[GALLERY] Nissan nhá hàng SUV Tekton đậm chất Patrol, "đối thủ" Kia Seltos](https://cdn.kienthuc.net.vn/images/fa6fa22794e1049e63e79fd6d1d3f051aa2f09cb5010a93da44658e5ded0d5cc701a69cd11302c0c104f53d3993bdfcd/11-1912.jpg.avif)

![[GALLERY] Mazda CX-5 thế hệ mới "cháy hàng" nhận 10.000 đơn chỉ sau 1 tháng](https://cdn.kienthuc.net.vn/images/fa6fa22794e1049e63e79fd6d1d3f051aa2f09cb5010a93da44658e5ded0d5cc2b20e389e8931413b0c20e1edab75815/1-3360.jpg.avif)
Mazda CX-5 2026 mới đang tạo nên sức hút lớn tại Nhật Bản khi ghi nhận hơn 10.000 đơn đặt hàng chỉ sau một tháng mở bán, cao gấp 5 lần so với mục tiêu ban đầu.
![[GALLERY] Skoda Peaq 2027 vừa ra mắt - SUV điện 3 hàng ghế chạy 647 km/sạc](https://cdn.kienthuc.net.vn/images/fa6fa22794e1049e63e79fd6d1d3f051aa2f09cb5010a93da44658e5ded0d5ccfcaf26fad2b90e7bcccfd89a226e5054/3-4638.jpg.avif)
Skoda vừa ra mắt SUV điện Skoda Peaq 2027. Đây là mẫu SUV điện đầu bảng mới của Skoda, sở hữu cấu hình 3 hàng ghế và kích thước lớn hơn cả Skoda Kodiaq,
![[GALLERY] Tính năng AI miễn phí của Google gây sốt, người Việt dùng cực nhiều](https://cdn.kienthuc.net.vn/images/fc6b1457645b26575fcbba0a62d9d7d427a43aec4d7578e6a2066dc2517e12a4baf95a50518cc744c6184e1388024d95/ni-1.png.avif)
Gemini và NotebookLM của Google đang thu hút hàng triệu người dùng nhờ loạt tính năng AI miễn phí mạnh mẽ.
![[GALLERY] Máy ảnh compact 20 năm tuổi bất ngờ sốt trở lại nhờ Gen Z](https://cdn.kienthuc.net.vn/images/fc6b1457645b26575fcbba0a62d9d7d4be365bfc1f9dc885057affd4daacee682c9e4462ec7548a38f72f636d0d161fc/anh-2.png.avif)
Từng bị smartphone lấn át, máy ảnh compact đời cũ bất ngờ hồi sinh mạnh mẽ khi Gen Z săn lùng để theo đuổi phong cách ảnh vintage và Y2K.
![[GALLERY] BYD Denza N8L 2027 từ hơn 1,1 tỷ đồng, chạy 430km không "ăn xăng"](https://cdn.kienthuc.net.vn/images/fa6fa22794e1049e63e79fd6d1d3f051aa2f09cb5010a93da44658e5ded0d5cc4493aa30b0408a06c2b4a4559307ee2c/11-4458.jpg.avif)
Mẫu xe BYD Denza N8L 2027 mới mở bán tại thị trường Trung Quốc được trang bị bộ pin LFP có dung lượng 75,26 kWh và phạm vi di chuyển thuần điện tăng lên 430 km.
![[GALLERY] Nissan nhá hàng SUV Tekton đậm chất Patrol, "đối thủ" Kia Seltos](https://cdn.kienthuc.net.vn/images/fa6fa22794e1049e63e79fd6d1d3f051aa2f09cb5010a93da44658e5ded0d5cc701a69cd11302c0c104f53d3993bdfcd/11-1912.jpg.avif)
Hãng xe Nissan mới đây tiếp tục hé lộ những hình ảnh mới của mẫu SUV cỡ trung Tekton 2027 trước thềm màn ra mắt toàn cầu dự kiến diễn ra vào ngày 9/7/2026.
![[GALLERY] Mark Zuckerberg chi 15 tỷ USD mua thiên tài 29 tuổi, giờ ra sao?](https://cdn.kienthuc.net.vn/images/fc6b1457645b26575fcbba0a62d9d7d4cf048880028638b5a5a90c4a05bc07c8fe11c5ed1042dcaa0a9762cfe4a53f99/thien-2.png.avif)
Sau một năm được Meta chi 15 tỷ USD để chiêu mộ, thiên tài AI Alexandr Wang đang dần chứng minh canh bạc táo bạo của Mark Zuckerberg là đúng đắn.
![[GALLERY] Audi A3 2027 trình làng với nội thất "xịn sò", giá từ 36.300 USD](https://cdn.kienthuc.net.vn/images/fa6fa22794e1049e63e79fd6d1d3f051aa2f09cb5010a93da44658e5ded0d5cc9666213d3a10691b70f77a6b90b0fcca/13.jpg.avif)
Mẫu xe Audi A3 2027 đã được áp dụng những tinh chỉnh nhỏ ở cả ngoại thất lẫn nội thất, bao gồm màn hình cong toàn cảnh cùng hệ thống hỗ trợ lái tiên tiến hơn.
![[GALLERY] Bỏ gần 4 triệu mua Office vĩnh viễn, giờ chỉ còn để xem tài liệu?](https://cdn.kienthuc.net.vn/images/fc6b1457645b26575fcbba0a62d9d7d4563789aada2798b51f972cb4ae45e10ef69fa7cad2394be6e48f0cfa26d0be0d/cro-1.png.avif)
Hàng triệu người dùng Office 2019 for Mac sắp mất khả năng chỉnh sửa tài liệu dù từng bỏ gần 4 triệu đồng mua bản quyền trọn đời, gây tranh cãi lớn.

Xem tử vi hàng ngày, tử vi 12 con giáp hôm nay cho thấy tuổi Tỵ thay đổi tư duy làm việc và có tố chất kinh doanh, thu nhập tăng nhanh.
![[GALLERY] VinFast VF3 chạy điện thành xe cảnh sát ở Philippines và Indonesia](https://cdn.kienthuc.net.vn/images/fa6fa22794e1049e63e79fd6d1d3f051aa2f09cb5010a93da44658e5ded0d5cc82a427937f72860a6b10223865e16be2/3.jpg.avif)
VinFast VF3 vừa được lực lượng Cảnh sát Quốc gia Philippines đưa vào sử dụng. Bên cạnh đó, xe còn hỗ trợ hoạt động tuần tra cho Cảnh sát giao thông Indonesia.
![[GALLERY] Lionel Messi sở hữu siêu xe nhưng kín tiếng, đẳng cấp chẳng kém ai](https://cdn.kienthuc.net.vn/images/fa6fa22794e1049e63e79fd6d1d3f051aa2f09cb5010a93da44658e5ded0d5cc9f40bf1669233fb77a6cd78f7972e8d9/1-5873.jpg.avif)
Dù không nổi tiếng trong lĩnh vực chơi xe nhưng bộ sưu tập xế hộp của siêu sao bóng đá Lionel Messi lại khiến nhiều người phải ngưỡng mộ vì mức độ chịu chơi.
![[GALLERY] CEO tặng nhân viên quà 78 triệu để ngủ, kết quả bất ngờ](https://cdn.kienthuc.net.vn/images/fc6b1457645b26575fcbba0a62d9d7d4765e42232aa9a645cf1ed549c555faf28c922ddf516fbe319f97e105e4276b6e/ngu-1.png.avif)
Thay vì tăng lương hay thưởng nóng, CEO một startup công nghệ chi 78 triệu đồng mỗi người cho thiết bị hỗ trợ ngủ, tạo nên câu chuyện gây chú ý.
![[GALLERY] iPhone cũ nào đáng mua nhất 2025? Câu trả lời gây bất ngờ](https://cdn.kienthuc.net.vn/images/fc6b1457645b26575fcbba0a62d9d7d45861dd458aa8818a9fed37cd9c2ee30d7574c5408b8781dbfab88ca138c72967/cu-4.png.avif)
Giá giảm mạnh nhưng hiệu năng vẫn vượt trội, nhiều mẫu iPhone cũ đang trở thành lựa chọn hấp dẫn, trong đó có một cái tên được đánh giá đáng mua nhất hiện nay.
![[GALLERY] SpaceX muốn phóng 1 triệu vệ tinh, biến vũ trụ thành siêu máy tính](https://cdn.kienthuc.net.vn/images/fc6b1457645b26575fcbba0a62d9d7d4c45ca36bd264948e42abc72b71e928668bf1d2f9272e973d1b5e7feea8ceab37/el-2.png.avif)
SpaceX đang ấp ủ kế hoạch táo bạo xây dựng mạng lưới 1 triệu vệ tinh AI, biến quỹ đạo Trái Đất thành siêu máy tính khổng lồ chưa từng có.
![[GALLERY] Toyota Urban Cruiser Ebella chính thức chốt giá 661 triệu đồng](https://cdn.kienthuc.net.vn/images/fa6fa22794e1049e63e79fd6d1d3f051aa2f09cb5010a93da44658e5ded0d5ccdd3509b23b5a971a33ea190de6215028/9-809.jpg.avif)
Mẫu xe SUV điện cỡ nhỏ Toyota Urban Cruiser Ebella mới đây đã được công bố giá bán sau hơn 1 năm ra mắt tại thị trường Ấn Độ, xe chỉ có duy nhất phiên bản E3.
![[GALLERY] Toyota RAV4 "cháy hàng", mở rộng sản xuất vẫn không đủ xe để bán](https://cdn.kienthuc.net.vn/images/fa6fa22794e1049e63e79fd6d1d3f051aa2f09cb5010a93da44658e5ded0d5cc25aa9f1dd2c738ab38a5f21099e80ed2/1-3357.jpg.avif)
Sức hút của mẫu xe SUV Toyota RAV4 2026 mới đang khiến nhiều đại lý tại Mỹ rơi vào tình trạng “cháy hàng”, khi lượng xe về đến đâu gần như được bán hết đến đó.
![[GALLERY] Pháp chọn hệ thống Thundart nội địa thay thế HIMARS](https://cdn.kienthuc.net.vn/images/8366023e10990871ea1458fbe73c9bf17fe4913da4a6b1476b87c47a567cdc6a503f92016d032b9b5bfc4bfdac255e9a/thundart.jpg.avif)
Hệ thống Thundart (sấm sét) do liên danh MBDA và Safran đã được lựa chọn để Pháp thay thế hệ thống pháo phản lực phóng loạt HIMARS vốn quá phụ thuộc vào Mỹ.
![[GALLERY] Từ bột ngọt đến chip AI, bí mật giúp Ajinomoto thống trị bán dẫn](https://cdn.kienthuc.net.vn/images/fc6b1457645b26575fcbba0a62d9d7d42b540b4a54436a3b2a9806330b8cfc2f8bf1d2f9272e973d1b5e7feea8ceab37/aj-2.png.avif)
Ít ai biết Ajinomoto không chỉ nổi tiếng với bột ngọt mà còn nắm giữ hơn 95% thị phần vật liệu ABF, mắt xích chiến lược của ngành chip AI toàn cầu.
![[GALLERY] Vật liệu vô danh đẩy giá bo mạch tăng vọt 40%](https://cdn.kienthuc.net.vn/images/fc6b1457645b26575fcbba0a62d9d7d4e30e2c229e807da9b7442b02bf8365123930b0e094e8da3d04e0eb98571b54d4/vat-2.png.avif)
Khủng hoảng nguồn cung nhựa PPE đang khiến giá bo mạch PCB tăng tới 40%, đe dọa kéo theo làn sóng tăng giá smartphone, laptop và thiết bị AI.